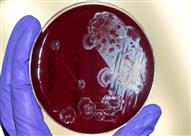

فشلت المضادات الحيوية في علاج هؤلاء المرضي ونجحت بكتيريا البراز
كتب - حاتم صدقي:
في أول دراسة محدودة من نوعها استخدمت ما يسمى بـ "زرع البراز" في علاج مرضي مصابين بعدوي خطيرة بالأمعاء.
وتم الحصول على "زرعات البراز" من أناس أصحاء، وأظهرت النتائج نجاح "زرع البراز" في علاج المرضى كأقوى المضادات الحيوية فاعلية.
وتذكر الإحصاءات الطبية أن جرثومة كلوستريديام ديفيسايل المعوية الخطيرة تقتل نحو 14 ألف انسان في الولايات المتحدة وحدها سنويا، وقد وجدت دراسة بحثية حديثة أن زرع بكتيريا البراز المأخوذة من انسان صحيح في أمعاء المريض المصاب بالجرثومة المعوية يعالجه بفاعلية تامة كأقوى المضادات الحيوية سواء بسواء.
ومن الممكن لجرثومة كلوستريديام ديفيسايل عندما تصيب انسان أن تتغلب على أمعاءه وتكون صعبة الاستئصال، وتسبب الحمى والقيء والتشنجات والإسهال الشديد لدرجة أنها تقتل ذلك العدد الكبير سنويا في الولايات المتحدة وحدها.
وتمثل المضادات الحيوية الخط الأول لعلاج الميكروب المهاجم "كلوستريديام ديفيسايل"، لكن مجموعة من الباحثين النرويجيين تساءلت عما إذا كان هناك شيء أخر غير مألوف مثل حقنة شرجية تحتوي على محلول من البكتيريا المأخوذة من براز أشخاص أصحاء وقد تنجح وتؤدي نفس النتيجة بالقضاء على جرثومة كلوستريديام ديفيسايل.
ووفقا للتقرير الحديث المنشور في مجلة نيو انجلاند للطب، فلم يتم حتى الآن إجراء أي تجربة سريرية موسعة في أكثر من مركز طبي واحد، والذي قام بإجراء تحقيقات حول ما يسمى بزرع البراز في الأمعاء كعلاج أول للعدوى الناجمة عن العدوى المعوية العنيفة، على حد قول الدكتور مايكل بريتهور، أخصائي أمراض الجهاز الهضمي بجامعة أوسلو بالنرويج والباحث الأول في هذه الدراسة الجديدة.
وقال الدكتور ألكسندر خوروتس، اخصائي أمراض الجهاز الهضمي في جامعة مينيسوتا، إن إدارة الأغذية والأدوية توافق على عمليات زرع البراز، ولكن فقط كملاذ أخير لعلاج عدوى الجهاز الهضمي بالجراثيم الصعبة التي تصيب الأمعاء، وذلك بعد فشل المضادات الحيوية.
وهناك اتفاقا كاملا بين هيئة الغذاء والدواء الأمريكية ومختلف الجمعيات المهنية بشأن هذه النقطة.
وتظهر عدة تجارب سريرية صغيرة خبرة الأطباء السريرية في زرع البراز كوسيلة فعالة يمكن أن يساعد في علاج هذه الحالة البالغة الصعوبة، وإنها بالتأكيد تمثل نقلة نوعية للعلاج. وتقول الدكتورة نادية سافدار، أخصائية الأمراض المعدية في جامعة ويسكونسن – ماديسون أن هذه الدراسة التي أجريت في النرويج تعد صغيرة الحجم حيث شملت عشرين مريضاً فقط تم اختيارهم بطريقة عشوائية للحصول على البكتيريا البرازية أو المضادات الحيوية والمقارنة بين النتائج في الحالتين، إلا أن هذا العدد لا يكفي لتحديد ما إذا كان زرع البراز أفضل من المضادات الحيوية.
ولذلك، كان هدف البحث الجديد هو إظهار أن نتائج العلاج بالبكتيريا البرازية ليست أسوأ من المضادات الحيوية. وفيه تم علاج خمسة من أصل تسعة مرضى تلقوا البكتيريا البرازية على الفور من التهاباتهم المعوية، مقارنة مع خمسة من 11 في المجموعة التي حصلت على المضادات الحيوية.
وحصل ثلاثة من المرضى الأربعة المتبقين من مجموعة البكتيريا البرازية على المضادات الحيوية، تم علاج اثنين في غضون أيام في حين لم يتم علاج أي من مرضى المضادات الحيوية التي استمرت أعراضها بعد الجولة الأولى من العلاج بجولة ثانية من الأدوية على الرغم من أن النتائج كانت تبدو لصالح العلاج بالبكتيريا البرازية، إلا أن الفرق لم يكن كبيراً بما يكفي للقول بأن عمليات زرع البراز كانت أفضل من الأدوية.
ويخطط الباحثون حاليا لبدء دراسة أوسع على 200 مريض خلال هذا الصيف.
ومن الممكن استخراج البكتيريا من البراز وتوفيرها كحقن شرجية أو تعبئتها في كبسولات يبتلعها المرضى. كما تقوم شركة صغيرة بزرع البكتيريا البرازية معمليا وتجميدها بغرض عمليات الزرع. وقد اعتمدت الدراسة النرويجية-كما يقول الدكتور بريتهاور-على تلك الشركة لتزويدها بكبسولات البكتيريا البرازية، لكن الباحثين يقولون إن الشركة ليس لها دور آخر في الدراسة.
ويستكشف الباحثون استخدام عمليات زرع البراز في مجموعة متنوعة من الحالات، بدءا من أمراض الأمعاء مثل داء كرون والتهاب القولون المتقرح إلى أشياء بعيدة المنال، مثل التصلب المتعدد.
وتكمن أكثر الأدلة الواعدة لفعالية زرع البراز في علاج التهاب القولون المتقرح.
ويقول الدكتور خوروتس إن إحدى مشكلات استخدام زرع البراز كعلاج أخير للعدوى الناجمة عن العدوى العسيرة تكمن في أنه يمكن أن يمر وقت طويل قبل أن يتضح أن الأدوية قد فشلت.
وقال إنه في المتوسط، يعاني هؤلاء المرضى خلال عشرة أشهر من العلاج بالمضادات الحيوية غير المجدية قبل تجربة زرع برازي.
ومع ذلك، فإن بعض المرضى الذين تم تشخيصهم حديثًا كمصابين بالجرثومة الأكثر صعوبة، يسألون الدكتور خوروتس لماذا لا يستطيعون الحصول على كبسولات البكتيريا البرازية على الفور.
وأضاف أن المضادات الحيوية التي تدمر البكتيريا الطبيعية التي تحمي ضد جرثومة كلوستريديام الصعبة هي السبب الرئيسي الذي تطور العدوى في المقام الأول.
ويقول الدكتور خوروتس إن عمليات زرع البراز تحاول إصلاح ما تم كسره في المقام الأول، بدلاً من إدامة الضرر.
ولكن عندما اقترح الدكتور بريتهور وزملاؤه دراسة اختبار زرع البراز مقارنة بالمضادات الحيوية في المرضى الذين تم تشخيصهم حديثًا، ولم يكن الأطباء في البداية متحمسين لاستخدام البكتيريا البرازية، وقال الدكتور بريتهور إن وضع براز شخص في أمعاء مريض أخر، يجب أن يكون له سبب وجيه. وأضاف بإن المضادات الحيوية هي علاج معتمدوجميع الأطباء ملمون بجوانبه.
واقترح مجلس أخلاق البحث العلمي الذي من المحتم الحصول على موافقة على التجارب السريرية إجراء دراسة تجريبية مصغرة بدلا من ذلك.
وكان التحدي يتمثل في الوصول إلى المرضى قبل إعطاءهم المضادات الحيوية. ووافق فنيو المختبرات على تنبيه الباحثين إلى حالات مصابة بجرثومة كلوستريديام ديفيسايل العنيدة، كما سارع الباحثون بطلب تأجيل إعطاء الأطباء للمضادات الحيوية حتى يدخل المرضى في الدراسة.
وقال الدكتور بريتهاور، أن المرضي سيتحدثون عن أنفسهم، ولكن بعد استكمال تجربة أكبر حجما عندما يكون لديهم نتائج مقنعة يمكن أن تغير من الممارسة السريرية. قال الدكتور خوروتس إنه في انتظار التجربة السريرية الموسعة قبل استخدام زرع البراز كخط أول للعلاج ضد جرثومة كلوستريديام ديفيسايل، ولكن إذا سألتني عما إذا كانت والدتي قد حصلت على هذا العلاج الجديد، ثم قال "لن أنتظر" وكن سأبادر بتقديمها لعملية زرع البراز.